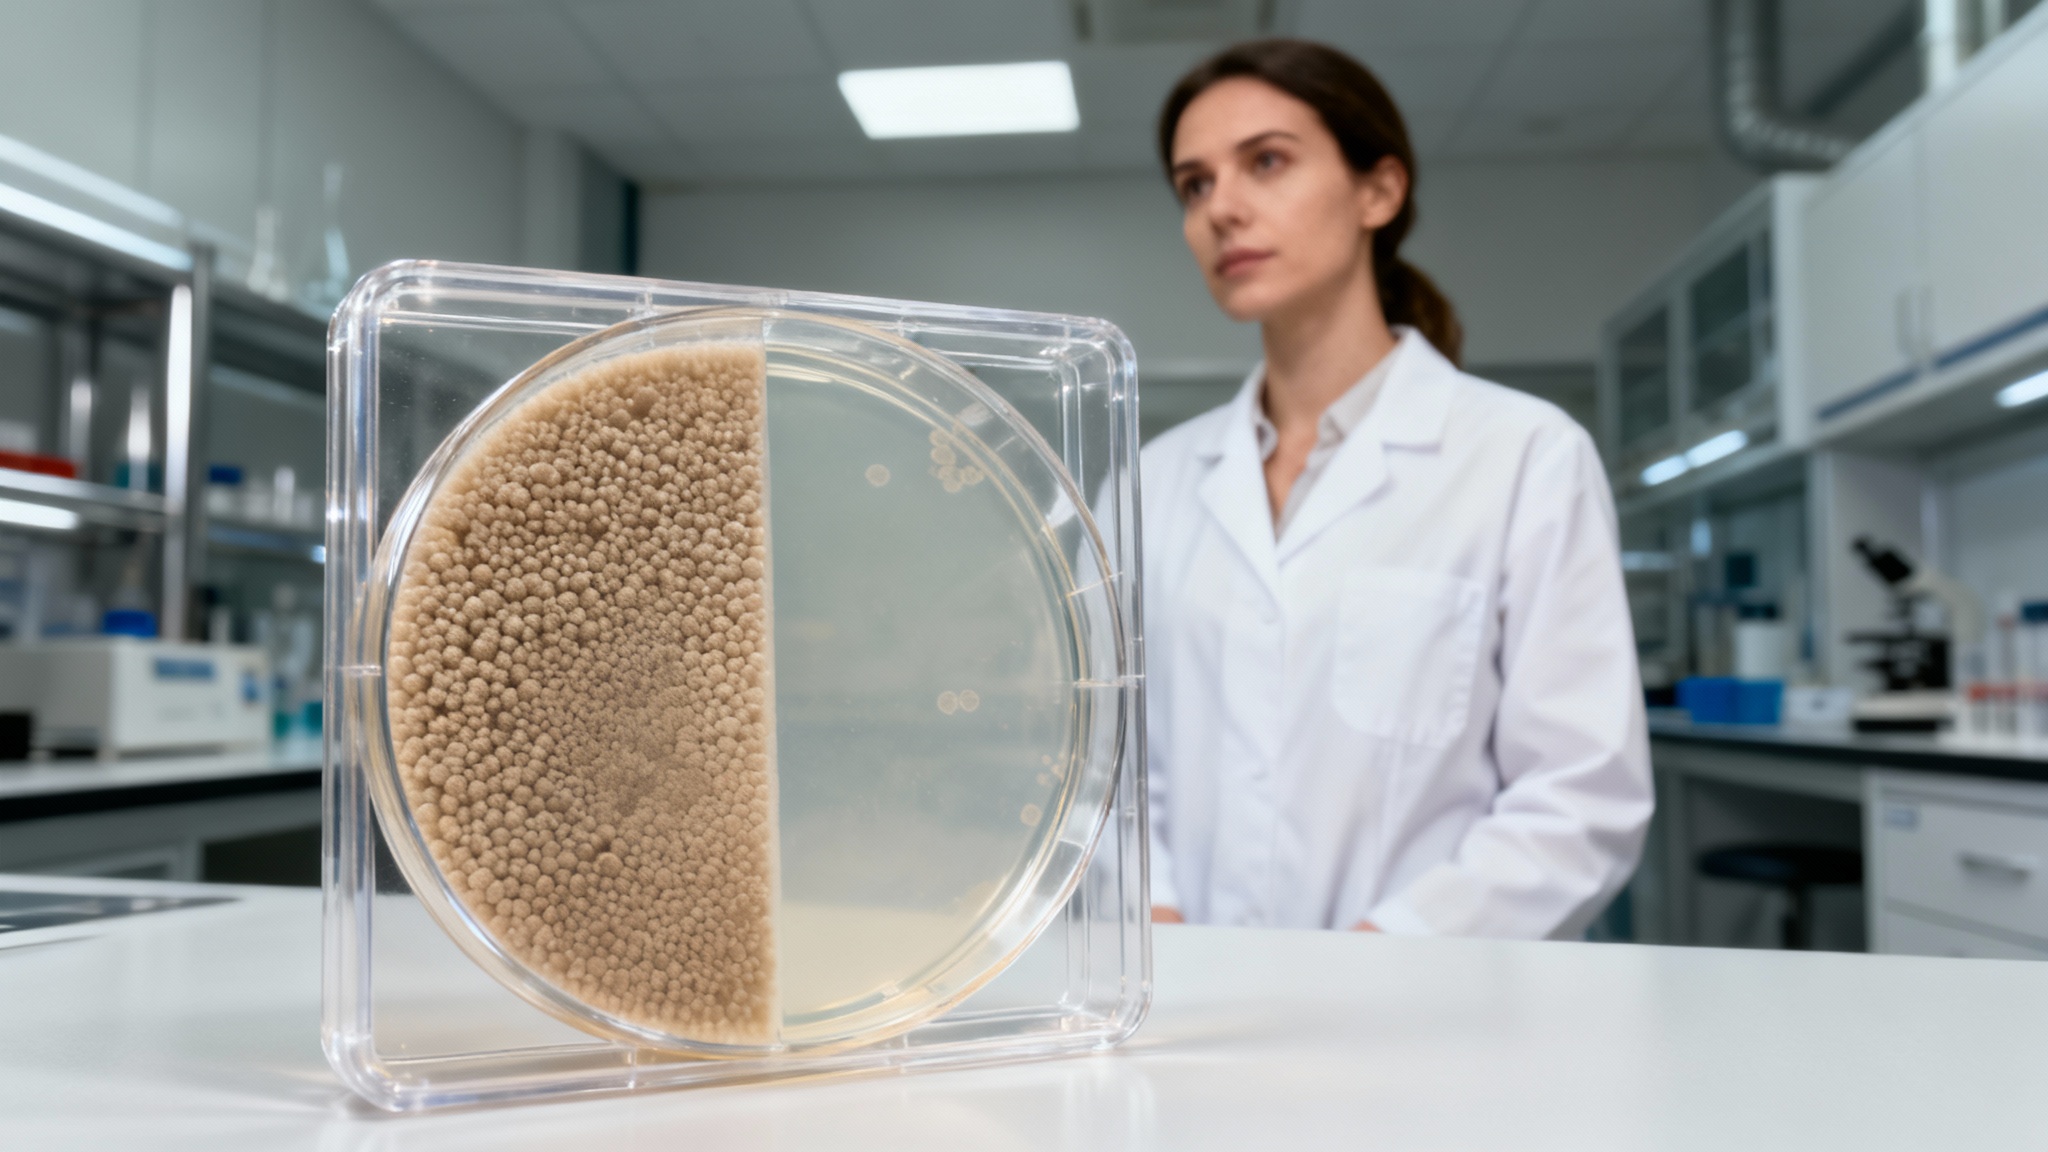

Des patchs intelligents pour des aliments plus sûrs : la fin des intoxications alimentaires ?
Auteur: Mathieu Gagnon
Un souci qui nous concerne tous

Les méthodes actuelles : un coup d’épée dans l’eau ?

Ces virus sont nos alliés : ils ne s’attaquent qu’aux mauvaises bactéries et sont inoffensifs pour nous. Le problème, c’est que ces sprays ne nettoient qu’en surface. Or, le danger se cache souvent au cœur même des aliments, là où rien ne peut l’atteindre.
L’invention qui change la donne : le patch à micro-aiguilles

L’idée est toute simple : on presse brièvement le patch sur un morceau de viande ou un autre aliment. Les micro-aiguilles pénètrent alors légèrement sous la surface, sans abîmer le produit. C’est simple, rapide, et ça ne se voit même pas.
Comment ça fonctionne exactement ?

Des résultats qui parlent d’eux-mêmes
Ils ont même essayé un ‘cocktail’ de différents virus pour viser à la fois E. coli et la salmonelle. Là encore, le succès était au rendez-vous, avec une réduction de 96,5% et 99,4% des bactéries respectivement. Franchement, c’est plus qu’encourageant.
Conclusion : Vers un futur sans crainte dans nos assiettes ?

Mais si tout se passe bien, cette technologie pourrait être utilisée directement sur les chaînes de production ou même intégrée dans les emballages. C’est une lueur d’espoir pour manger plus sereinement, en se passant des antibiotiques qui nous posent tant de problèmes. Une petite révolution, discrète mais terriblement efficace, pourrait bien être en marche.










